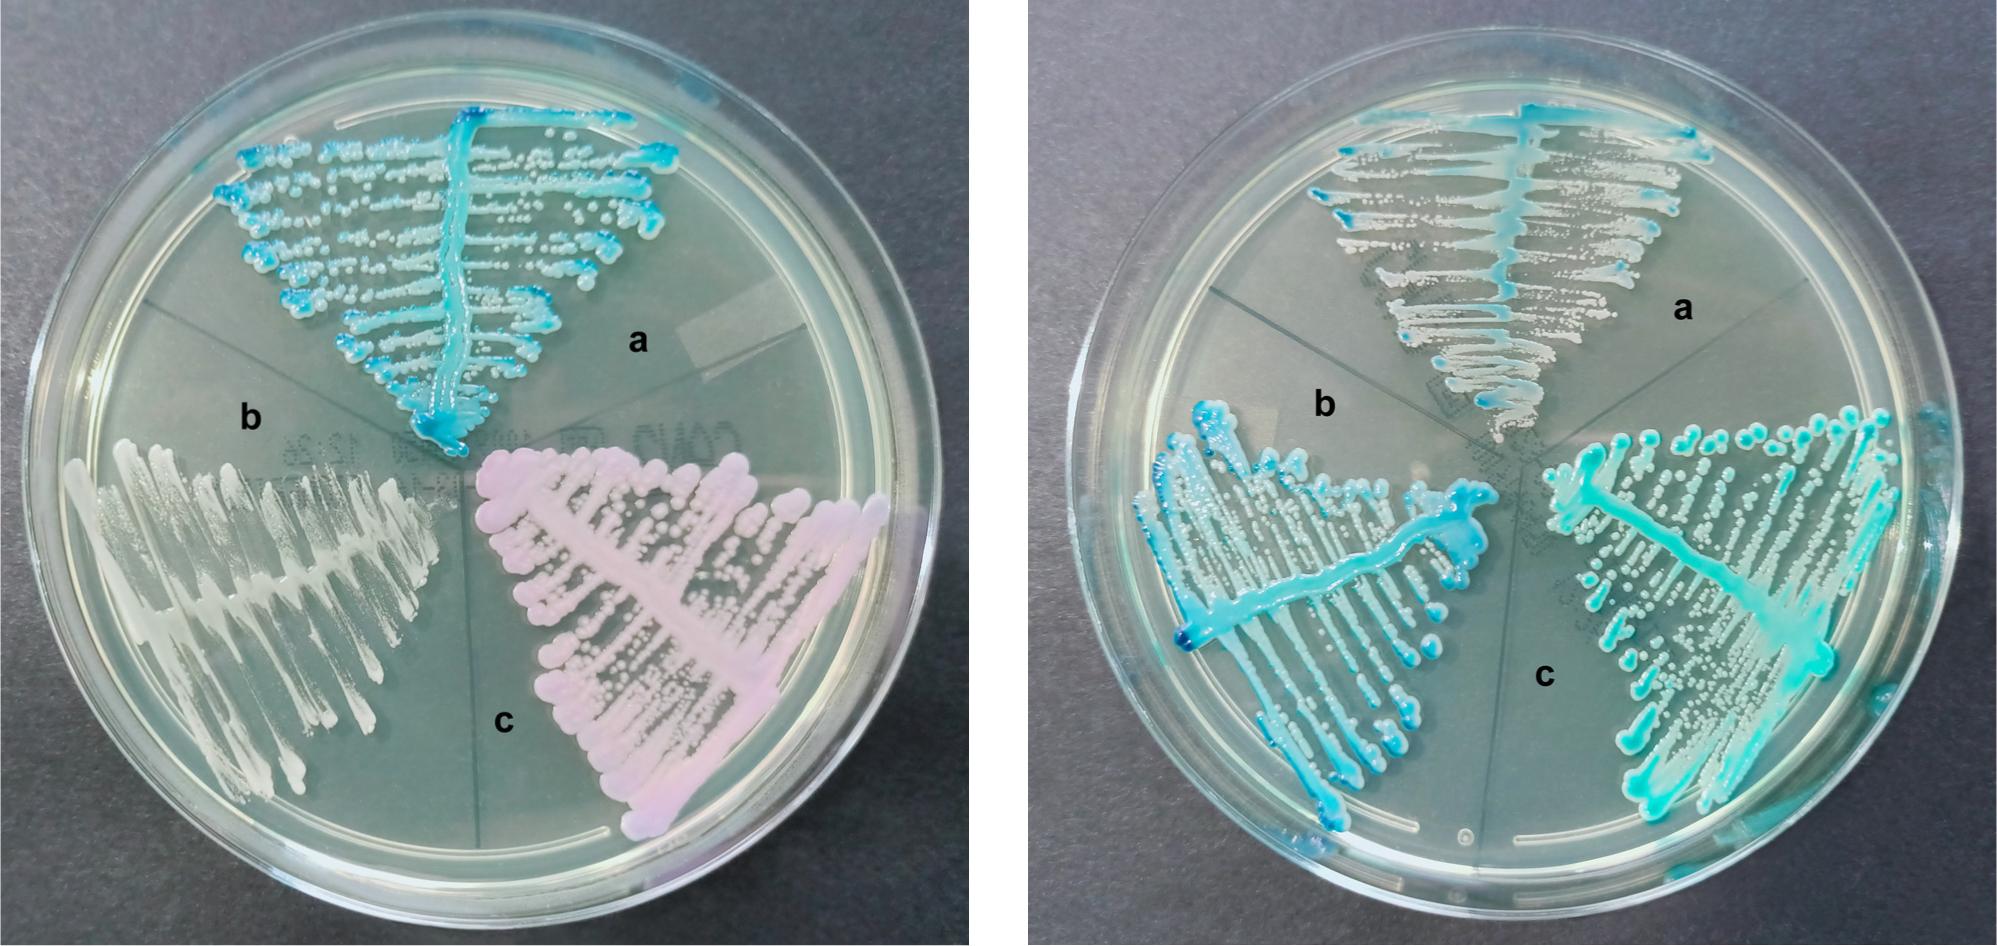
Morphology of reference strains of yeasts colonies after 48 h incubation in 37°C on chromID® Candida (bioMérieux, France).
A. a) Candida albicans ATCC® 90028™ (dark blue colonies), b) Candida glabrata ATCC® 2001™ (white colonies), c) Candida tropicalis ATCC® 9968™ (pink colonies).
B. a) Candida africana ATCC® MYA 2669™ (small, light blue colonies), b) Candida albicans ATCC® 90028™ (dark blue colonies), c) Candida dubliniensis clinical strain (turquoise colonies).

Fig. 1.
Fig. 2.

Fig. 3.

Percentage of compatible results obtained by the methods used to discriminate species among Candida albicans complex (VITEK®2 system and MALDI-TOF MS) with the hwp1 gene amplification with PCR_
| The compliance with PCR assay | ||
|---|---|---|
| VITEK 2 | 319 (97.85) | 7 (2.15) |
| MALDI-TOF MS | 323 (99.08) | 3 (0.92) |
Molecular discrimination among Candida albicans complex_
| Species | No. (%) n = 326 |
|---|---|
| Candida albicans | 307 (94.17) |
| Candida dubliniensis | 17 (5.21) |
| Candida albicans + Candida dubliniensis | 2 (0.61) |
Discrepancies between species identification among Candida albicans complex obtained by the Vitek®2 system, MALDI-TOF MS and the hwp1 gene amplification with PCR_
| Isolate No. | VITEK 2 | MALDI-TOF MS | PCR assay based on the hwp1 gene amplification | ||||
|---|---|---|---|---|---|---|---|
| Species identification | Confidence level (probability) | Species identification | Confidence level | Species identification | Product size (bp) | ||
| CA67 | clinical strain | Candida albicans/Candida dubliniensis | low (< 85%) | Candida dubliniensis | 99.90% | Candida dubliniensis | 569 |
| CA95 | clinical strain | Candida albicans | excellent (96%) | Candida albicans | 99.90% | Candida albicans + Candida dubliniensis | 941 + 569 |
| CA98 | clinical strain | not identified | – | Candida dubliniensis | 99.90% | Candida dubliniensis | 569 |
| CA125 | clinical strain | Candida ciferrii | acceptable (86%) | Candida dubliniensis | 99.90% | Candida dubliniensis | 569 |
| CA13 | clinical strain | Candida albicans/Candida dubliniensis | low (< 85%) | Candida dubliniensis | 99.90% | Candida dubliniensis | 569 |
| CA137 | clinical strain | Candida albicans | good (91%) | Candida albicans | 99.90% | Candida dubliniensis | 569 |
| CA313 | clinical strain | Candida albicans | very good | Candida albicans | 99.90% | Candida albicans + Candida dubliniensis | 941 + 569 |
| Candida albicans | reference strain | Candida albicans | excellent (98%) | Candida albicans | 99.90% | Candida albicans | 941 |
| Candida dubliniensis | reference strain | Candida dubliniensis | very good | Candida dubliniensis | 99.90% | Candida dubliniensis | 569 |
| Candida africana | reference strain | Candida dubliniensis/Candida parapsilosis | low (< 85%) | Candida albicans | 99.90% | Candida africana | 700 |
Prevalence of single VVC and co-occurrence with bacteria_
| Type of co-occurrence | No. (%) |
|---|---|
| Single VVC | 197 (60.43) |
| VVC + bacteria: | 129 (39.57) |
| Gardnerella vaginalis | 60 (18.40) |
| Streptococcus agalactiae | 41 (12.58) |
| Gardnerella vaginalis + Streptococcus agalactiae | 11 (3.37) |
| Escherichia coli | 9 (2.76) |
| Escherichia coli + Streptococcus agalactiae | 3 (0.92) |
| Gardnerella vaginalis + Escherichia coli | 2 (0.61) |
| Methicillin susceptible Staphylococcus aureus | 1 (0.31) |
| Streptococcus pyogenes | 1 (0.31) |
| Klebsiella pneumoniae + Streptococcus agalactiae | 1 (0.31) |